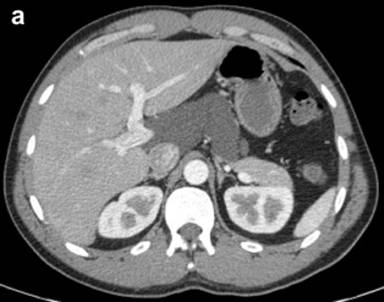

CASE REPORT
JOP. J Pancreas (Online) 2012 May 10; 13(3):282-284.
Pancreas Cystic Lymphangioma Diagnosed with EUS-FNA
Adam W Coe1, John Evans2, Jason Conway2
Departments of 1Internal Medicine and 2Gastroenterology, Wake Forest University Baptist Medical Center. Winston-Salem, NC, USA
ABSTRACT
Context Endoscopic ultrasound has proved to be an invaluable tool when obtaining high quality images of the pancreas. Furthermore, fine-needle aspiration of suspected lesions can be carried out simultaneously thus providing tissue samples for cytologic diagnosis. We present two cases of a rare pancreatic lesion that were diagnosed by endoscopic ultrasound with fine-needle aspiration. Case #1 A 60-year-old asymptomatic gentleman was found to have an incidental pancreatic lesion on abdominal computed tomography scan during a cardiac workup. Patient had no personal or family medical history that would predispose him to pancreatic lesions. Endoscopic ultrasound was performed and patient was diagnosed with pancreatic cystic lymphangioma. Case #2 A 40-year-old asymptomatic gentleman with history of heavy alcohol use was found to have an incidental pancreatic lesion on computed tomography scan during a work up of chest pain. Computed tomography guided fine-needle aspiration was negative for malignancy but no other studies were performed on the fluid sample at that time. Patient was then referred to our institution after repeat computed tomography scan showed a stable lesion. Endoscopic ultrasound did not show evidence of pancreatitis and fine-needle aspiration was consistent with pancreatic cystic lymphangioma. Discussion The universally available and escalating use of computed tomography scans has led to an increased detection of incidental cystic pancreatic lesions. Pancreatic cystic lymphangiomas are a rare lesion and account for less than one percent of all pancreatic cystic lesions. These lesions are easily and accurately diagnosed by the use of endoscopic ultrasound guided fine-needle aspiration.
INTRODUCTION
Endoscopic ultrasound (EUS) has been shown to be an effective modality in providing high resolution images of the pancreas [1]. These images are crucial when attempting to ascertain the etiology of pancreatic cystic lesions. Additionally, EUS can guide fine-needle aspiration (FNA) of suspected lesions and provide fluid for analysis. We present two cases of pancreatic cystic lymphangioma (PCL) diagnosed by EUS-FNA which add to the six cases previously reported in the literature.
CASE REPORTS
Case #1
A 60-year-old asymptomatic male was found to have an abdominal cystic lesion incidentally on computed tomography (CT) scan of the coronary vessels during routine cardiology work up in preparation for an ablation of atrial fibrillation. (Figure 1a). The patient subsequently underwent transabdominal ultrasound which showed a multiloculated anechoic cystic mass adjacent to the body and head of the pancreas. No evidence of pancreatic or biliary duct dilation was seen. The patient has no history of heavy alcohol use (Figure 1b). There was no personal or family history of pancreatic or hepatobiliary disease. Physical examination was unremarkable including no evidence of abdominal tenderness or masses. Routine laboratory tests at the time were all normal including: serum electrolytes, complete blood count, and biochemical tests of hepatic and renal function.


|
Figure 1. a. Contrast enhanced abdominal CT scan showing a cystic lesion adjacent to the head of the pancreas and anterior to the right kidney from Case #1. b. Linear EUS image showing the anechoic cyst with several thin septae from the same patient. |
Curved linear-array EUS (GF-UCT140, Olympus America Co., Center Valley, PA, USA) was performed and a large 9x8 cm anechoic cyst was noted adjacent to the caudate lobe of the liver and the head of the pancreas. There were several thin septations within the cyst but no associated solid masses or mural nodules were seen. The imaged portions of the liver, pancreas, and biliary tree were otherwise normal. The largest loculation closest to the transducer was aspirated using a 19 gauge EUS-FNA needle (Echotip® Ultra, Cook Medical Inc., Winston-Salem, NC, USA) and 200 mL of thick yellow-white, chylous appearing fluid was removed. The laboratory analysis of the cystic fluid revealed a carcinoembryonic antigen (CEA) level less than 0.5 ng/mL (reference range: 0-3 ng/mL), an amylase level of 70 U/L (reference range: 0-10 U/L), and a triglyceride level of 798 mg/dL (reference range: 0-10 mg/dL). Cytologic evaluation was negative for malignancy and showed only benign epithelial cells with a few scattered lymphocytes on the smear. A diagnosis of pancreatic cystic lymphangioma was made and no further diagnostic testing such as immunostaining was conducted. Patient was offered surgical referral for removal but declined and has subsequently been followed for 20 months. He remains asymptomatic and repeat CT scans have shown no change in the cyst.
Case #2
A 40-year-old asymptomatic male with history of heavy alcohol use was found to have an abdominal fluid collection on a CT scan during work up for mild chest discomfort. Endoscopic retrograde cholangiopancreatography (ERCP) was then performed which showed a normal pancreatic duct and had no communication with the fluid collection. CT-guided FNA of this lesion revealed cytology that was negative for malignancy and remarkable for only scant macrophages. No amylase, lipase, or CEA was sent on the fluid at that time. The medical history is otherwise only remarkable for mild hypertension for which patient takes no medications. Physical examination was unremarkable including no evidence of abdominal tenderness, masses, or hepatosplenomegaly.
The patient was referred to our institution after a CT scan four months later showed the peripancreatic cyst stable in size measuring 9.0x4.5 cm (Figure 2a). Curved linear-array EUS showed a multiseptated cystic process near the head of the pancreas. The pancreas demonstrated some lobularity but did not meet EUS criteria for chronic pancreatitis (Figure 2b). The lesion was aspirated using the 19 gauge EUS-FNA needle and 5 mL of milky-white fluid was obtained. Laboratory analysis of the cystic fluid revealed a CEA of 2.0 ng/mL and an amylase of 276 U/L. Cytology was negative for malignancy, showed only benign appearing lymphocytes on the smear, and felt to be consistent with diagnosis of pancreatic cystic lymphangioma. Given the small amount of fluid aspirated, a triglyceride level was unable to be obtained due to partial solidification of material prior to analysis. No further diagnostic testing such as immunostaining was performed and patient was referred for surgical evaluation. Unfortunately, the patient failed to make this appointment and was lost to follow-up.

|
Figure 2. a. Contrast enhanced abdominal CT scan showing a cystic lesion adjacent to the body of the pancreas and extending into the porta hepatis from Case #2. b. Linear EUS image showing the anechoic cyst with several thin septae from the same patient. |
DISCUSSION
The widespread use and availability of advanced imaging modalities such as CT scan and transabdominal ultrasound have led to increased detection of incidental cystic lesions of the pancreas. The most common cystic lesion of the pancreas is a pseudocyst which accounts for approximately 90% of all pancreatic cystic lesions [2]. Lymphangiomas are benign lesions that originate from lymphatic vessels and occur most commonly in children [3]. Histologically, pancreatic cystic lymphangiomas consist of interconnecting cysts separated by septa, lined by epithelial cells, and contain serous, serosanguineous, or chylous fluid [4]. Lymphangiomas typically arise in the head, neck, and axilla region (95%); pancreatic cystic lymphangiomas are extremely rare subgroup and account for less than 1% of all lymphangiomas and only 0.2% of pancreatic lesions [5]. As in the case of our two patients, these lesions are usually discovered as an incidental finding in asymptomatic patients undergoing workup for another disease process [5].
EUS is an excellent imaging modality for evaluation of pancreatic lesions. EUS is able to provide the examiner with detailed high resolution images of the lesion and the surrounding area including adjacent vasculature. Unfortunately, the EUS morphology of pancreatic cystic lymphangiomas can overlap those of more concerning pancreatic lesions such as mucinous cystic neoplasms [6]. The ability to safely obtain cyst fluid for analysis during EUS can improve the diagnostic yield compared to EUS alone [6]. The performance characteristics of EUS-FNA are quite impressive as specificity of 100 and accuracy of 86% has been reported in the literature [7]. The diagnosis of pancreatic cystic lymphangioma is made if the aspirated fluid is chylous in appearance and has an elevated triglyceride level [4]. If the fluid aspirated is serous and only has a mildly elevated triglyceride level then further diagnostic workup or surgical referral may be necessary. Although, we were unable to analyze the fluid triglyceride level in our second case, the diagnosis of pancreatic cystic lymphangioma was felt to be appropriate given the EUS findings, appearance of the fluid on aspiration, and the cytology results. No malignant transformation of pancreatic cystic lymphangiomas has been reported in the literature. Expectant management with follow-up is a reasonable approach; however, the possibility remains in these patients for hemorrhage, torsion, rupture, obstruction and infection especially in the setting of any abdominal trauma. This potential should be weighed against the risks of surgery which by most reports is curative in these patients [8].
Received December 23rd, 2011 - Accepted January 17th, 2012
Key words Biopsy, Fine-Needle; Endosonography; Lymphangioma; Pancreatic Cyst
Disclosures The authors have nothing to disclose regarding this manuscript
Correspondence
Adam W
Coe
Wake Forest University Baptist Medical Center
Medical Center Boulevard
Winston-Salem, NC 27157
USA
Phone: +1-336.716.9106
Fax: +1-336.716.2273
E-mail: acoe@wakehealth.edu
References
1. R. Sedlack, A. Affi, E. Vazquez-Sequeiros, I.D. Norton, J.E. Clain and M.J. Wiersema, Utility of EUS in the evaluation of cystic pancreatic lesions, Gastrointest Endosc 56 (2002), pp. 543–547. PMID: 12297771
2. L.V. Hernandez, G. Mishra, C. Forsmark, P.V. Draganov, J.M. Petersen and S.N. Hochwald et al., Role of endoscopic ultrasound (EUS) and EUS-guided fine needle aspiration in the diagnosis and treatment of cystic lesions of the pancreas, Pancreas 25 (2002), pp. 222–228. PMID 12370531
3. H. Abe, K. Kubota, T. Noie, Y. Bandai and M. Makuuchi, Cystic lymphangioma of the pancreas: a case report with special reference to embryological development, Am J Gastroenterol 92 (1997), pp. 1566–1567. PMID 9317093
4. Jathal A, Arsenescu R, Crowe G, Movva R, Shamoun DK. Diagnosis of pancreatic
cystic lymphangioma with EUS-guided FNA: report of a case. Gastrointest Endosc. 2005 Jun; 61(7):920-922. PMID 15933705
5. E. Paal, L.D. Thompson and C.S. Heffess, A clinicopathologic and immunohistochemical study of ten pancreatic lymphangiomas and a review of the literature, Cancer 82 (1998), pp. 2150–2158. PMID 9610694
6. B.C. Bounds and W.R. Brugge, EUS diagnosis of cystic lesions of the pancreas, Int J Gastrointest Cancer 30 (2001), pp. 27–31. PMID 12489578
7. Raddaoui E., Clinical utility and diagnostic accuracy of endoscopic ultrasound-guided fine needle aspiration of pancreatic lesions: Saudi Arabian experience. Acta Cytol. 2011; 55(1): 26-29. PMID 21135518
8. Sanaka M.R., Kowalski T.E. Cystic lymphangioma of the pancreas. Clinical Gastroenterology and Hepatology 2007; 5(3): 10–11. PMID 17368224